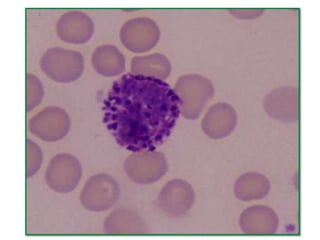

O documento descreve os principais tipos e características do tecido conjuntivo no corpo humano. Apresenta informações sobre as células, fibras e substância fundamental que compõem o tecido conjuntivo, bem como os tipos de tecido conjuntivo frouxo, denso, adiposo, cartilaginoso, ósseo e sanguíneo. Por fim, inclui exercícios sobre os componentes e funções desses tecidos.